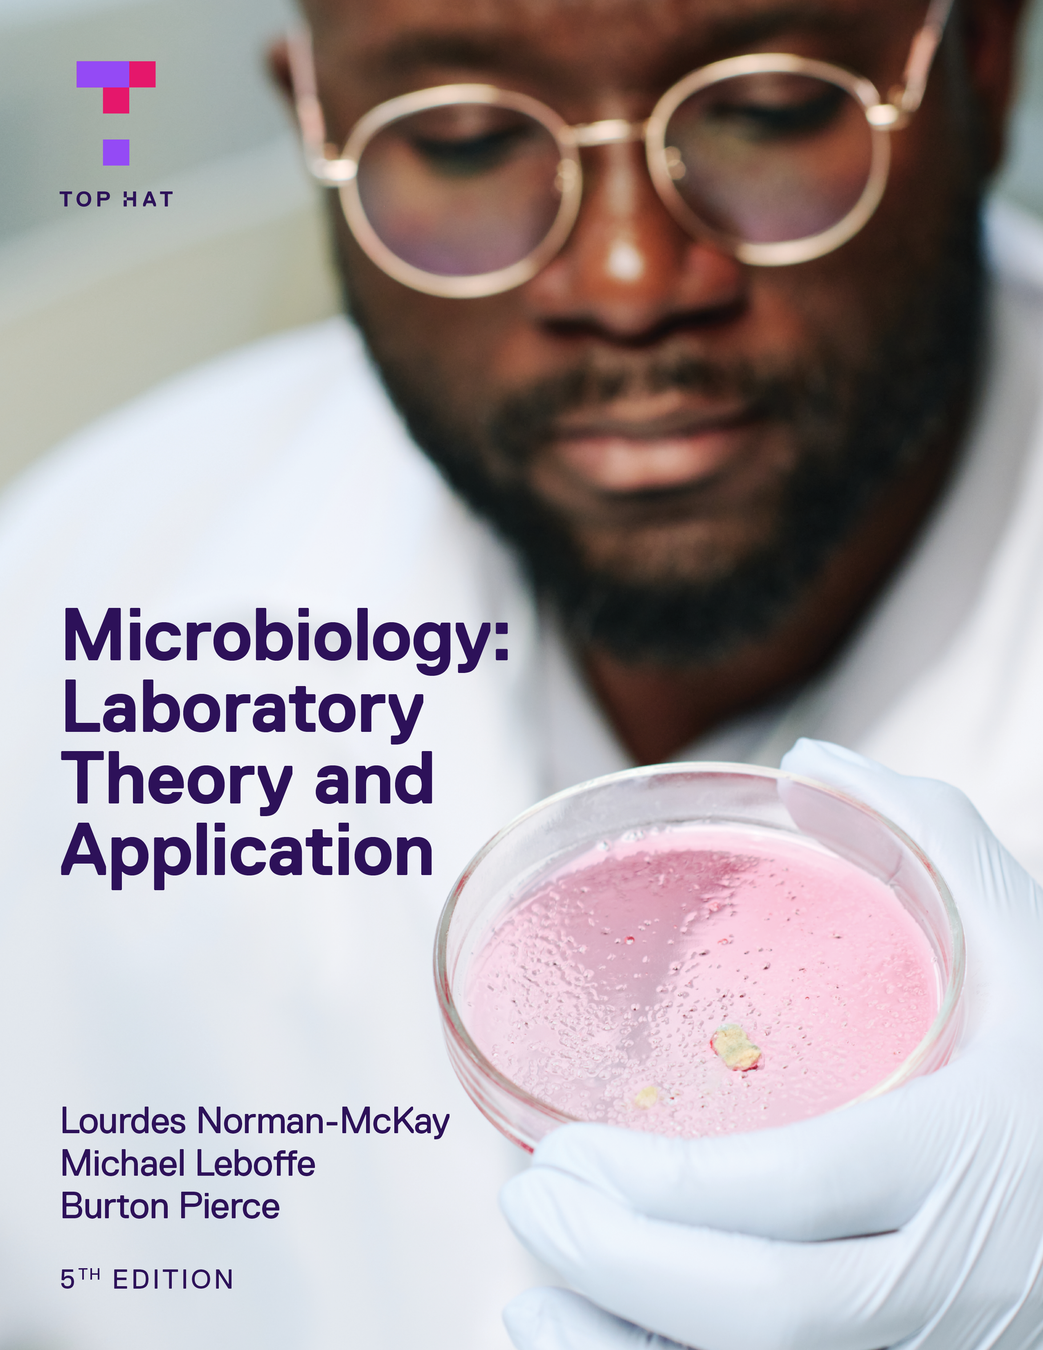
Microbiology: Laboratory Theory and Application, 5e cover photo

Microbiology: Laboratory Theory and Application, 5e
Lourdes Norman-McKay, Michael Leboffe, Burton Pierce
For courses with majors or mixed majors with an emphasis on clinical and applied microbiology. Beautiful full-color photography, effective illustrations, more than 100 carefully written exercises, and a reasonable price combine to make Microbiology: Laboratory Theory & Application the best-selling microbiology lab manual series on the market. This edition satisfies the content needs of courses populated by majors or in non-majors courses where an increased coverage of applied microbiology is desired.

Top Hat Interactive eText
requires a join code from instructor
$83.00USD
all prices represent net price, not including 3rd party markups
Hybrid
requires a join code from instructor
$93.00USD
all prices represent net price, not including 3rd party markups
Table of Contents for Microbiology: Laboratory Theory and Application, 5e
- Front Matter
- Introduction: Safety in the Microbiology Laboratory
- Section 1 Fundamental Skills for the Microbiology Laboratory
- Section 2 Introduction to Growing Bacteria
- Section 3 Staining Bacteria
- Section 4 Survey of Selective and Differential Media
- Section 5 Biochemical Tests for Identifying Bacterial Isolates
- Section 6 Differentiating Streptococcus and Staphylococcus Species
- Section 7 Additional Bacteria Identification Methods
- Section 8 Environmental Conditions Affecting Bacterial Growth
- Section 9 Controlling Bacterial Growth
- Section 10 Microbial Enumeration Methods
- Section 11 Molecular Biology Techniques
- Section 12 Medical Microbiology
Key features
- More than 100 exercises covering a full selection of clinical and applied microbiology topics that feature beautiful photography, easy-to-understand illustrations, and carefully written activities to help teach microbiological techniques and show students the impact of microbes on our daily lives
- Pre-labs include auto-gradable questions to assure your students are arriving prepared
- The post-lab includes auto-gradable assessments and critical thinking questions to allow student to demonstrate their mastery of the assigned learning objectives